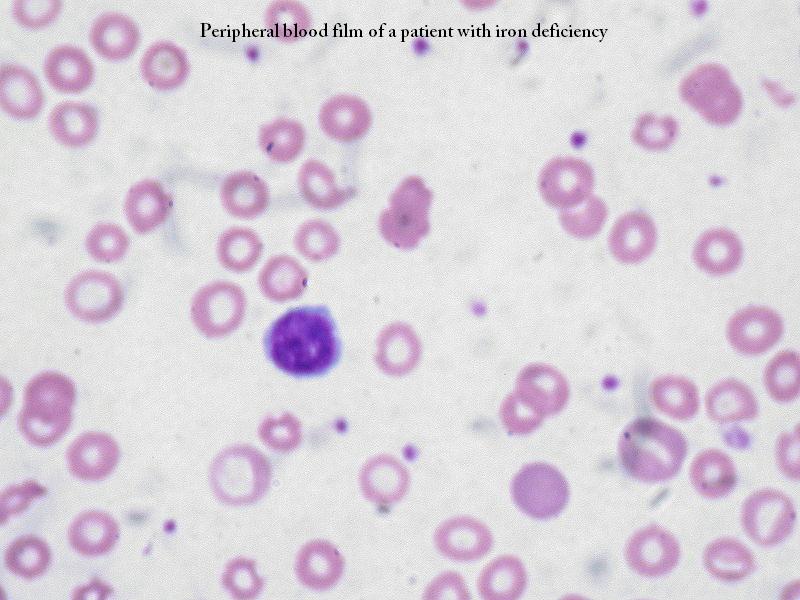

Tags
arthritis, Chronic (medicine), Conditions and Diseases, Disease, Health, Inflammation, Musculoskeletal Disorders, Rheumatoid Arthritis, Scleritis
Rheumatoid Arthritis (RA) Complications
Think of rheumatoid arthritis (RA) and you probably think of the stiff, painful, and inflamed joints that characterize the disease. But what you might not know is that RA complications can occur in many parts of the body. The autoimmune process that wreaks havoc on the joints can also affect the eyes, lungs, skin, heart and blood vessels, and other organs. The medications you take for RA can have unwanted side effects as well. And, dealing with a chronic disease like RA day in and day out may cause emotional distress. Many people with RA suffer from depression.
To manage the complications of rheumatoid arthritis, it’s important to recognize problems early and get appropriate treatment. Here are some potential problems you should be aware of:
Effects on the Skin
 One-fifth of people with rheumatoid arthritis develop lumps of tissue called rheumatoid nodules, usually under the skin, particularly on the elbows, forearms, heels, or fingers. The nodules, which may develop gradually or appear suddenly, can be an indication of more severe disease activity. Rheumatoid nodules can also occur in other areas of the body, such as the lungs and heart.
One-fifth of people with rheumatoid arthritis develop lumps of tissue called rheumatoid nodules, usually under the skin, particularly on the elbows, forearms, heels, or fingers. The nodules, which may develop gradually or appear suddenly, can be an indication of more severe disease activity. Rheumatoid nodules can also occur in other areas of the body, such as the lungs and heart.
RA-related inflammation of the blood vessels, or vasculitis, can cause changes to the skin and surrounding tissue that can appear as ulcers.
Other types of rashes or skin changes related to RA or medications may be seen in patients. It’s important to alert your doctor regarding any skin rash or sores.
Eye Complications
 Rheumatoid arthritis can affect the eyes in several ways. Inflammation of the episclera, a thin membrane that covers the sclera, or white of the eye, is a common complication of RA. It is usually mild, but the eye can become red and painful. Scleritis, inflammation of the white of the eye, is more serious and can lead to vision loss.
Rheumatoid arthritis can affect the eyes in several ways. Inflammation of the episclera, a thin membrane that covers the sclera, or white of the eye, is a common complication of RA. It is usually mild, but the eye can become red and painful. Scleritis, inflammation of the white of the eye, is more serious and can lead to vision loss.
Having rheumatoid arthritis also puts you at risk of Sjogren’s syndrome, a condition in which the immune system attacks the lacrimal glands, which produce tears. This can cause your eyes to feel gritty and dry. If not treated, dryness can lead to infection and scarring of the conjunctiva (the membrane that covers the eye) and cornea. If you have rheumatoid arthritis, ask your doctor about the need for regular eye exams.
Heart and Blood Vessel Disease
 Many people with rheumatoid arthritis have a collection of fluid between the pericardium and the heart itself (called a pericardial effusion), but not all will have clinical symptoms from it. Episodes of pericarditis (inflammation of the membrane that surrounds the heart) usually develop during flares, or periods of heightened disease activity.
Many people with rheumatoid arthritis have a collection of fluid between the pericardium and the heart itself (called a pericardial effusion), but not all will have clinical symptoms from it. Episodes of pericarditis (inflammation of the membrane that surrounds the heart) usually develop during flares, or periods of heightened disease activity.
Persistent pericarditis can lead to thickening and tightening of the membrane, which can interfere with the heart’s ability to work properly. Lesions similar to rheumatoid nodules can also develop on the heart and affect heart function. Inflammation of the heart muscle itself (myocarditis) is a rare complication.
Drugs used for RA treatment may also weaken the heart and other muscles.
Systemic inflammation puts people with RA at increased risk of cardiovascular disease. Recent research shows that people with RA have an increased risk of heart attack that is about the same as for people with type 2 diabetes. Having RA also increases risk of stroke.
Inflammation of blood vessels, called vasculitis, is an uncommon but serious complication of rheumatoid arthritis. Vasculitis associated with RA, called rheumatoid vasculitis, more commonly affects the small blood vessels supplying the skin, but it can affect many of the body’s organs, including the eyes, heart, and nerves.
Diseases of the Blood and Blood-Forming Cells
Most people with active RA experience a reduction in red blood cells called anemia. Anemia may cause symptoms such as fatigue, rapid heart beat, shortness of breath, dizziness, leg cramps, and insomnia. Active inflammation may also lead to high levels of blood platelets, while treatment to suppress the immune system may lead to low levels of blood platelets, a condition called thrombocytopenia.
 Another possible, but uncommon complication of RA is Felty’s syndrome, a condition in which the spleen is enlarged and the white blood cell count is low in people with rheumatoid arthritis. Having Felty’s syndrome may increase the risk of lymphoma, a cancer of the lymph glands.
Another possible, but uncommon complication of RA is Felty’s syndrome, a condition in which the spleen is enlarged and the white blood cell count is low in people with rheumatoid arthritis. Having Felty’s syndrome may increase the risk of lymphoma, a cancer of the lymph glands.
Lung Problems
The inflammatory process that affects the lining of the heart can similarly affect the membrane lining the lungs, leading to pleuritis and fluid collection.
 Rheumatoid nodules also can form in the lungs. In most cases, the nodules are harmless, but can possibly lead to problems such as a collapsed lung, coughing up blood, infection, or pleural effusion — the accumulation of fluid between the lining of the lung and the chest cavity. Interstitial lung diseases and pulmonary hypertension can also develop as complications of RA.
Rheumatoid nodules also can form in the lungs. In most cases, the nodules are harmless, but can possibly lead to problems such as a collapsed lung, coughing up blood, infection, or pleural effusion — the accumulation of fluid between the lining of the lung and the chest cavity. Interstitial lung diseases and pulmonary hypertension can also develop as complications of RA.
RA treatments can affect the lungs, as well. For example, one of the most commonly used RA treatments, methotrexate, can potentially cause lung problems, characterized by shortness of breath, cough, and fever. Symptoms tend to improve when methotrexate is stopped.
Susceptibility to Infection
People with RA are more prone to infections, which may be related to the underlying disease itself or the immune-suppressing medications used to treat it. Studies show that treatment with biologic agents, a relatively new and effective class of RA treatment, may greatly increase the risk of serious infections in people with RA.
Emotional Effects
 Living day to day with the pain and limitations of a chronic disease can take a toll on your emotional as well as physical health. One recent study showed that almost 11% of people with RA had moderately severe to severe symptoms of depression. Those who were rated as being more restricted in their normal activities were significantly more likely to have depression. The study also showed that only one in five patients who showed symptoms of depression discussed it with their arthritis doctor.
Living day to day with the pain and limitations of a chronic disease can take a toll on your emotional as well as physical health. One recent study showed that almost 11% of people with RA had moderately severe to severe symptoms of depression. Those who were rated as being more restricted in their normal activities were significantly more likely to have depression. The study also showed that only one in five patients who showed symptoms of depression discussed it with their arthritis doctor.
Protect Yourself From RA Complications
Although you may not think to mention problems like depression, chest pain, or dry eyes to the doctor treating your rheumatoid arthritis, it’s important that you do so. All of these problems can be related to your arthritis. Although different problems may require different doctors and/or different treatments, often a change in arthritis treatment — either to better control the disease or to eliminate the side effects of a certain treatment — can be an important step in managing or resolving all of these problems.
Further Reading:
Related articles
- Rheumatoid Arthritis Inflammation Increases Chance Of Heart Disease Related Death [Study] (inquisitr.com)
- What is serum negative rheumatoid arthritis (wiki.answers.com)
- 15 Surprising Facts About Rheumatoid Arthritis (huffingtonpost.com)
- New genetic clue in the development of rheumatoid arthritis (medicalxpress.com)
- Inflammation from Rheumatoid Arthritis Tied to Heart Disease (nlm.nih.gov)
- Defect in A20 gene expression causes rheumatoid arthritis (eurekalert.org)
- What is lifespan of one with rheumatoid arthritis (wiki.answers.com)
- Defect in A20 gene expression causes rheumatoid arthritis (medicalxpress.com)
- Rheumatoid Arthritis is definitely not for wimps (livinglifewithraandfms.wordpress.com)
- Welcome to www.rheumindia.wordpress.com! Help in spreading awareness! (rheumindia.wordpress.com)

Pingback: Foot Pain and Rheumatoid Arthritis « TweenLik Live
Pingback: Joint Stiffness and Rheumatoid Arthritis « Earl's View